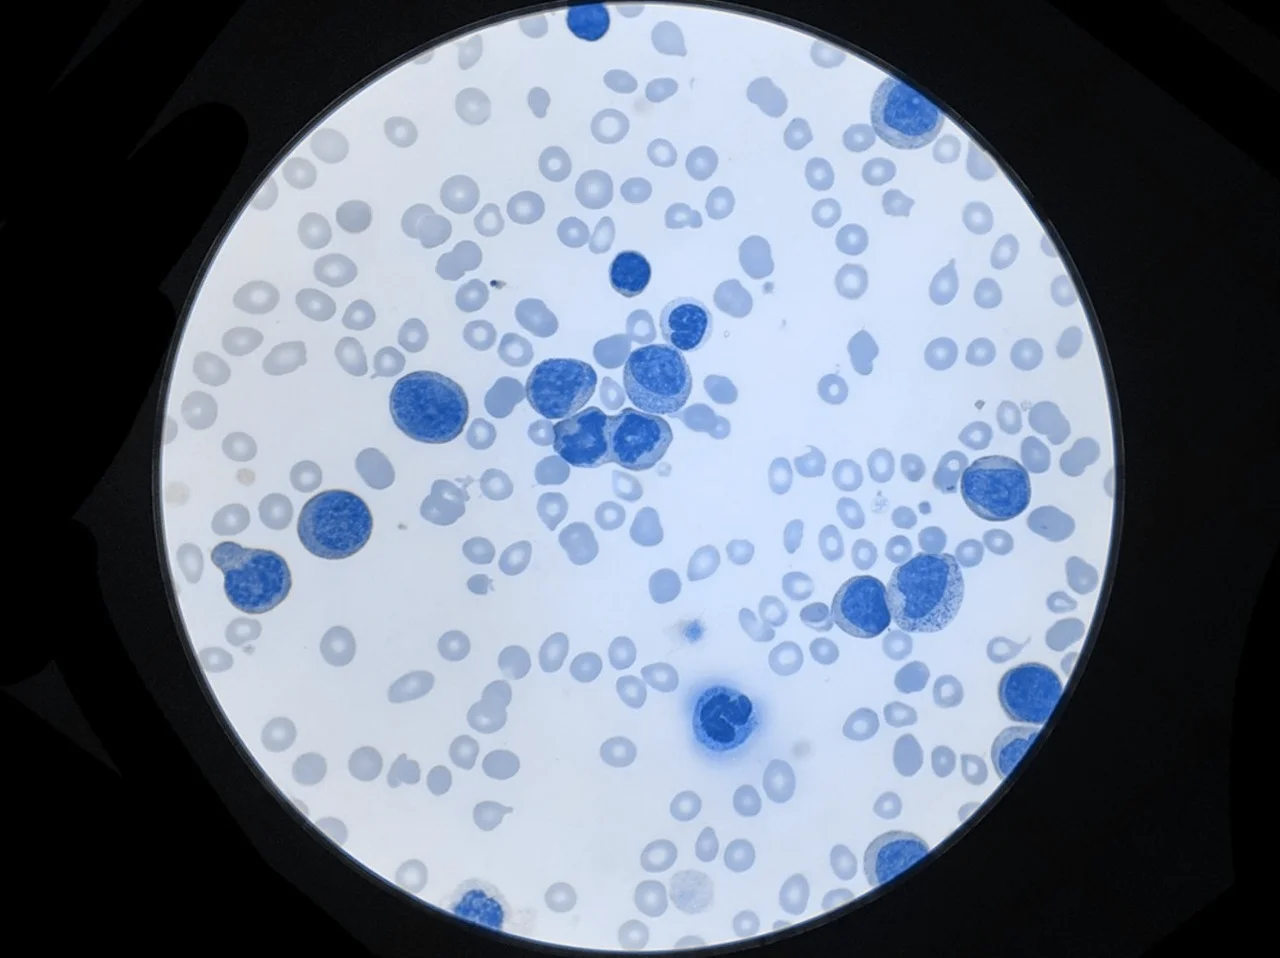
Célula de linfoma ampliada bajo un microscopio, como parte del estadio patológico para determinar las etapas del cáncer. Célula de linfoma ampliada bajo un microscopio, como parte del estadio patológico para determinar las etapas del cáncer.

El diagnóstico de una neoplasia maligna marca el inicio de un proceso complejo donde la precisión es fundamental para la supervivencia. Las etapas del cáncer representan la forma en que los especialistas categorizan la extensión de la enfermedad en el cuerpo, permitiendo que tanto médicos como pacientes hablen un mismo lenguaje. Comprender si estamos ante un cáncer etapa 1 o un proceso más avanzado es el primer paso para definir la ruta terapéutica, ya que cada nivel implica desafíos y pronósticos distintos que deben ser analizados con rigor científico y sensibilidad humana.
Abordar la estadificación del cáncer es de vital importancia porque de ella depende directamente la elección del tratamiento, ya sea cirugía, quimioterapia o radioterapia. Un diagnóstico erróneo de la etapa podría llevar a intervenciones insuficientes o, por el contrario, a tratamientos excesivamente agresivos que deterioren la calidad de vida del paciente sin necesidad. Saber con exactitud cuántas etapas tiene el cáncer ayuda a reducir la incertidumbre, permitiendo que las familias se preparan emocionalmente y que se asignen los recursos adecuados para combatir la enfermedad de manera efectiva.
En la actualidad, el campo de la oncología vive una revolución gracias a la medicina de precisión y el análisis genómico. El presente nos permite utilizar herramientas de imagen avanzadas para determinar los estadios del cáncer de mama u otros órganos con una claridad nunca antes vista.
El sistema TNM: el estándar internacional de clasificación
Para entender qué es la estadificación del cáncer y por qué es necesaria, debemos conocer el lenguaje técnico que utilizan los oncólogos a nivel mundial. El sistema TNM es la herramienta principal para describir la anatomía de un tumor. Esta nomenclatura permite que un médico en cualquier parte del mundo entienda la gravedad del caso simplemente leyendo unas siglas en el expediente clínico. Sin este sistema, la comunicación entre especialistas sería ambigua, lo que dificultará la colaboración internacional en investigaciones y ensayos clínicos.
El significado de las siglas T, N y M
La letra T se refiere al tamaño y la extensión del tumor principal (primario). Se suele numerar del 1 al 4, donde un valor más alto indica que la masa ha crecido más o se ha infiltrado en tejidos adyacentes. La N describe si el cáncer ha alcanzado los ganglios linfáticos cercanos; estos son pequeños filtros del sistema inmunitario que suelen ser los primeros lugares a donde viajan las células cancerosas. Finalmente, la M indica si existe metástasis, es decir, si el cáncer se ha desplazado a órganos distantes del sitio original, lo cual es determinante para definir un cáncer etapa 4.
Cómo influyen los grados celulares en el sistema TNM
Además de las medidas físicas, los médicos evalúan el grado histológico, que analiza qué tan «anormales» se ven las células bajo el microscopio. Aunque el TNM mide la extensión, el grado celular nos dice qué tan rápido es probable que crezca el tumor. Un cáncer con un TNM bajo, pero un grado celular alto, puede comportarse de manera agresiva, lo que obliga a los especialistas a considerar tratamientos combinados incluso en etapas que inicialmente parecen tempranas o localizadas.
Diferencia entre el estadio clínico y el estadio patológico
Es común que los pacientes se confundan al recibir diferentes clasificaciones durante su proceso. La estadificación del cáncer no es un evento único, sino un proceso que puede ir actualizándose.
Por otra parte, el estadio clínico es una estimación inicial basada en lo que el médico puede ver y sentir a través de exámenes físicos, biopsias iniciales y estudios de imagen como tomografías o resonancias magnéticas. Es la “imagen” inicial que guía la primera decisión terapéutica.
El papel de la cirugía en el estadio patológico
¿Por qué pueden cambiar los resultados entre estadios?
La diferencia surge porque las pruebas de imagen tienen límites de resolución. Es posible que una tomografía no detecte grupos microscópicos de células cancerosas en los ganglios que solo el análisis patológico puede identificar.
Por esta razón, el estadio patológico suele considerarse más preciso. Es fundamental que los pacientes comprendan que este ajuste en la información no significa un error médico, sino un refinamiento de la estrategia para asegurar que el combate contra las etapas del cáncer de mama o de cualquier otro tipo sea lo más certero posible.
La importancia de la biopsia en la clasificación inicial
Antes de cualquier cirugía, la biopsia es el estándar de oro para la clasificación clínica. Sin una muestra de tejido, es imposible saber si una masa detectada por rayos X es realmente cancerosa o benigna. Este procedimiento proporciona las primeras pistas sobre la agresividad del tumor y ayuda a predecir si el paciente responderá mejor a un tratamiento sistémico previo a la cirugía, técnica conocida como terapia neoadyuvante.
Clasificación según la extensión
Una forma más sencilla de comprender las etapas de cáncer, utilizada frecuentemente por los registros estadísticos, es dividir la enfermedad por su alcance en el cuerpo. Esta terminología ayuda a los pacientes a visualizar la situación sin perderse en los tecnicismos del sistema TNM.
En términos generales, cuanto más confinada esté la enfermedad, mayores son las probabilidades de un tratamiento satisfactorio, de manera más localizada.
- Cáncer localizado: el tumor se encuentra estrictamente dentro del órgano donde comenzó, sin evidencia de haberse propagado. Aquí es donde solemos encontrar el cáncer etapa 1.
- Cáncer regional: la enfermedad se ha extendido a los tejidos cercanos o a los ganglios linfáticos adyacentes. Esto suele abarcar lo que conocemos como cáncer etapa 2 y parte de la etapa 3.
- Cáncer distante: las células cancerosas han viajado a través del torrente sanguíneo o el sistema linfático hacia órganos lejanos, como el hígado, los pulmones o los huesos, clasificándose como cáncer etapa 4.

Entendiendo la complejidad del cáncer etapa 3
El cáncer etapa 3 es a menudo el punto de inflexión más complejo en la oncología. Se considera una enfermedad regionalmente avanzada; el tumor es grande o ha invadido múltiples ganglios linfáticos, pero aún no se ha detectado en órganos distantes. El tratamiento aquí suele ser multimodal, requiriendo un esfuerzo coordinado de varios especialistas para evitar que las células residuales inicien un proceso de metástasis en el futuro cercano.
El reto del cáncer etapa 4 y la metástasis
Cuando hablamos de un cáncer etapa 4, nos referimos a un proceso sistémico. En este punto, el objetivo principal suele pasar de la «cura» al «control» de la enfermedad, tratándola como una condición crónica. Gracias a los avances médicos, muchas personas con etapa 4 viven años con una excelente calidad de vida, utilizando terapias dirigidas que atacan específicamente las mutaciones del tumor sin dañar tanto las células sanas.
Pronóstico y supervivencia según la extensión
Es vital entender que el pronóstico varía drásticamente según la extensión. Las estadísticas muestran que la detección en etapa localizada ofrece tasas de supervivencia muy altas, superiores al 90% en muchos casos de etapas del cáncer de mama. Por ello, las campañas de salud pública insisten tanto en la detección temprana; cuanto antes se identifique en qué nivel de las etapas del cáncer se encuentra el paciente, más herramientas tendremos para ofrecer un desenlace positivo.
En el área de Detección de Cáncer del Centro Médico ABC te podemos dar atención especializada ¡Contáctanos!
Preguntas Frecuentes
Fuentes:
MedlinePlus, Cancer.org, NIH